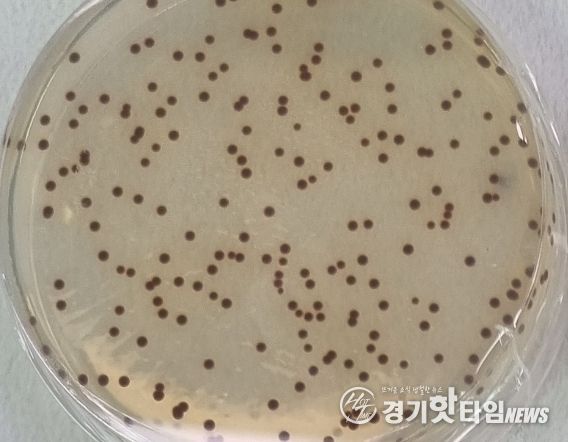

[경기핫타임뉴스=김삼영 기자] 경기도농업기술원이 새롭게 발굴한 광합성 균이 작물의 성장을 촉진하고 생산량을 늘린다는 조사 결과가 나왔다.
경기도농업기술원은 3월부터 5월까지 파주시농업기술센터와 함께 광합성 균을 파주시 친환경 오이 재배 농가 1곳에 공급해 생육 상태와 생산량을 조사했다.
광합성 균은 일반적으로 빛 에너지를 이용해 광합성 작용을 하는 세균으로 식물 생장 촉진 물질을 생산해 뿌리와 줄기의 발달, 꽃과 과실 발생 등을 돕는 것으로 알려져 있다. 도 농업기술원은 논, 하천 등지에서 광합성 균을 수집해 식물 호르몬 생성이 우수한 로도박터 캡슐라터스(Rhodobacter capsulatus)를 작물 적용 효과를 확인하기 위해 파주시 농업기술센터와 공동연구를 추진했다. 연구 방법은 광합성 균을 물에 100배 희석해서 일주일에 한 번씩 작물 잎에 뿌려주는 형태로 공급했다.
3개월간의 조사 결과, 광합성 균을 뿌려준 오이는 그렇지 않은 오이에 비해 초장(땅 위로 올라온 식물 부분. 작물의 키)이 7.2% 더 길었고, 암 꽃수 역시 22.2%가 많아 성장을 촉진하는 것으로 나타났다. 생산량은 광합성 균을 뿌려준 오이가 약 3톤으로 광합성 균을 사용하지 않은 오이 생산량인 2.4톤보다 25.7% 더 많았다.
임갑준 농업기술원 친환경미생물연구소장은 “이번 도-시군 공동연구를 계기로 도에서 선발한 미생물의 효능을 농가 현장에서 확인할 수 있도록 협업 체계를 지속적으로 확대해 나가겠다”라면서 “발굴한 광합성 균은 각 시군에 확대 보급하겠다”라고 말했다.
